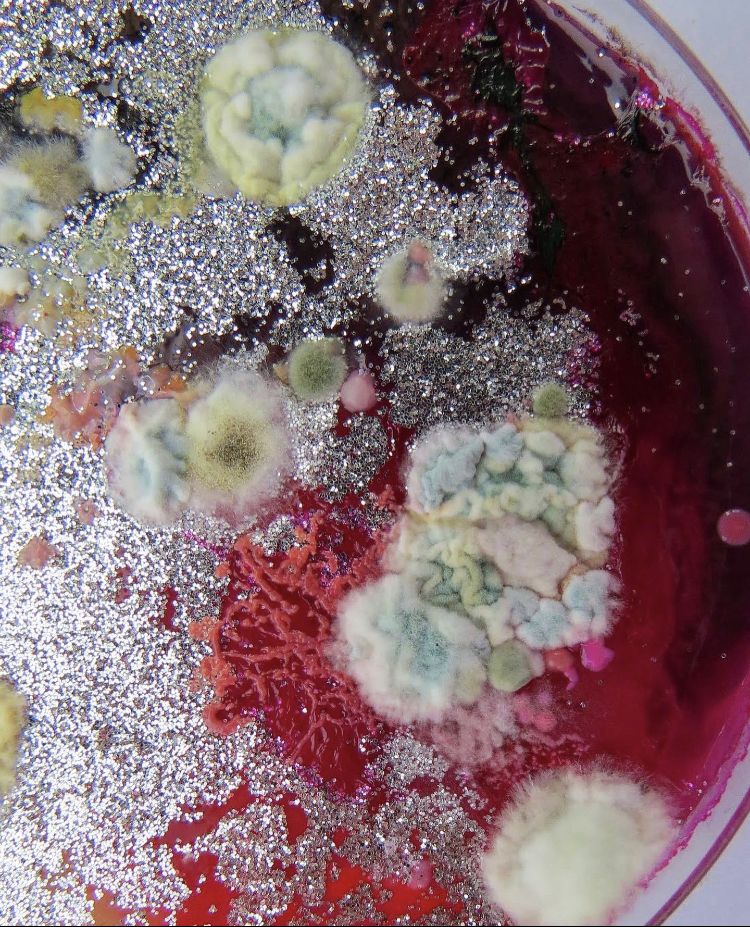

아이를 키우는 부모라면 누구나 아이의 발달과 건강에 대해 끊임없이 걱정하게 됩니다.
특히 요즘 들어 주목받는 주제 중 하나가 바로 곰팡이 노출이
신경 발달과 자폐 스펙트럼 장애 ASD와 어떤 관련이 있는가 하는 점입니다.
단순히 공기 질이나 환경 문제를 넘어 분자 수준에서
곰팡이가 신경과 면역 시스템에 영향을 줄 수 있다는 과학적 증거가 점차 늘어나고 있습니다.
이 글에서는 해외 연구와 국내 자료를 함께 살펴보며
곰팡이 노출과 ASD 간의 잠재적 연결 가능성을 정리해 보겠습니다.
중요 내용 요약본
현재까지의 증거는 일부 기전적 근거와 연관 연구를 보여 주지만 곰
팡이 노출이 ASD를 직접적으로 유발한다고 결론 내리기엔 근거가 불충분합니다.
다만 마이코톡신과 미생물 유래 면역자극이 태아 영유아의 신경발달에
영향을 줄 수 있다는 타당한 생물학적 경로가 제시되어 있습니다.
과학적 포인트 요약
1.역학적 신호와 혼재된 결과
일부 역학 연구와 사례 보고에서 주거 내 습기 및 곰팡이 노출과
ASD 관련 지표의 증가가 관찰되었다는 보고가 있습니다.
그러나 연구 설계의 차이, 노출 평가의 한계, 교란변수 통제 부족으로 결과가 일관적이지 않습니다.
소규모 사례군에서는 유의한 차이를 찾기도 했고 반대 결과를 보고한 연구도 있습니다.
따라서 인과성을 확정하기에는 아직 증거가 부족합니다.
2.마이코톡신과 신경독성 기전
일부 곰팡이에서 생성되는 마이코톡신은 세포 내 단백질 합성 저해, 산화 스트레스 유발, 미토콘드리아
기능 방해 같은 세포독성 경로를 통해
신경세포에 영향을 줄 수 있음을 보여 주는 전임상 세포 수준 데이터가 존재합니다.
이러한 기전은 발달 중인 뇌에 비정상적 신경회로 형성이나 신경염증을 유도할 가능성을 제시합니다.
3.모체 면역활성화 MIA 경로의 연결 가능성
현대 신경발달 연구에서 모체 면역활성화 MIA는 ASD 위험 증가와 강하게 연결된 설명 축입니다.
바이러스나 박테리아 감염뿐 아니라 환경 독소가 모체의 사이토카인 반응을 증폭하면
IL-6 같은 매개체가 태반을 통해 태아에 영향을 주어
신경회로 발달을 교란할 수 있다는 분자 동물 모델 근거가 풍부합니다.
곰팡이나 그 부산물이 모체 염증 반응을 촉발할 수 있다면 MIA 축을 통해
간접적으로 ASD 위험에 영향을 줄 가능성이 이론적으로 존재합니다.
4.장내 신체 미생물총과 면역 교란
ASD 아동에서 장내 미생물 불균형이 보고되는 가운데
일부 연구는 진균류의 비정상적 증식이나 곰팡이 대사물 흔적이
ASD 아동의 소변에서 검출되었다는 보고를 제시합니다.
이 데이터는 곰팡이 유래 대사산물이 장축 또는 면역축을 통해
신경발달에 간접 영향을 줄 수 있다는 가설을 지지합니다.
다만 추적 연구와 기전 증명이 더 필요합니다.
과학적 근거의 한계
강한 근거
마이코톡신의 세포 동물 수준 신경독성 증거.
모체 면역활성화 MIA가 태아 뇌발달에 미치는 영향에 대한 풍부한 전임상·임상 간접 증거.
약하거나 논쟁적인 영역
인체 역학 연구는 혼재되어 있음.
일부는 연관을 보고하나 표본수, 노출 측정 방법, 잠재적 교란요인 미조정 등 한계가 큼.
마이코톡신이 일상적 환경 노출 수준에서 태아 뇌발달을 직접 손상시키는지에 대한 인체 데이터는 아직 부족함.
기술적 정리
1.마이코톡신 직접 독성 경로
마이코톡신은 리보솜 기능 저해, 단백질 합성 차단, 산화스트레스 촉발을 통해
뉴런의 생존과 시냅스 형성에 부정적 영향을 줄 수 있음.
동물 및 세포 연구에서 신경세포 사멸과 신경발생 장애가 관찰됩니다.
2.면역매개 경로 MIA
곰팡이 유래 물질 또는 곰팡이로 인한 감염 자극이 모체의 염증성 사이토카인 증가로 이어지면
IL-6 같은 매개체가 태반을 통해 태아 뇌 환경에 영향을 미쳐 신경 회로의 분화와 시냅스 형성을 교란할 수 있음.
이 경로는 바이러스성 MIA에서 광범위하게 입증된 기전이며 곰팡이 관련 자극도 이 축에 포함될 수 있음.
3.장축 및 대사물질 경로
곰팡이나 곰팡이 대사물에 의한 장내환경 변화가 미세아교세포 활성이나
신경전달물질 전구체 대사에 영향을 끼쳐 행동 및 발달 결과에 영향을 줄 수 있다는 가설적 경로가 존재함.
일부 연구에서 ASD 아동의 장내 진균 대사물 패턴 특이성이 보고됨.
임상적 공중보건적 시사점
현재 부모와 임상의가 취할 실무적 조치
임신 중과 영유아 공간에서의 습기 누수 가시적 곰팡이 제거가 합리적 예방 전략입니다.
WHO 실내공기 가이드라인은 습기 원인 제거를 최우선으로 권고합니다.
환경 개선은 호흡기 질환뿐 아니라 잠재적 신경발달 영향 완화에 도움이 될 수 있습니다.
과학적 불확실성으로 ASD 의심 사례에서
곰팡이 노출만으로 진단을 내리거나 공포를 조성해서는 안 됩니다.
임상평가와 표준화된 진단, 환경평가를 병행해야 합니다.
연구자 정책 입안자가 강화해야 할 영역
표준화된 노출 평가지표 개발과 장기간 추적 코호트 연구
인간 조직 기반 분자연구와 전임상 모델 간 연계로 노출 기전 결과의 인과 사슬을 검증하는 연구 필요
저자극 환경에서의 실증적 개입 연구로 환경 개선이 발달 결과에 미치는 효과를 정량화할 필요
마케터가 정리한 실행 체크리스트
보이는 곰팡이 즉시 제거와 누수 원인 수리
실내 상대습도 40-60퍼로 유지, 제습기·환기 활용
임신부와 영유아가 높은 습기 환경에 장시간 노출되지 않도록 주의
심한 오염 구역은 전문 복원 업체 의뢰, 단순 약품 처리만으로 끝내지 않기
의심 증상 발생 시 환경 데이터(사진 습도 로그 검사 결과)와 함께 소아청소년과 또는 발달전문의 상담 권장
참고 자료
Ratnaseelan AM 등. Effects of Mycotoxins on Neuropsychiatric Symptoms and Mechanisms.
De Santis B 등. Role of mycotoxins in the pathobiology of autism.
Serkan Y 등. Mycotoxin Exposure and Autism systematic review.
Gatto MR 등. State-of-the-science review of dampness and mould effects on mental health. Environmental Health Perspectives 2024.
Smith SE 등. Maternal immune activation alters fetal brain development study.
WHO Guidelines for Indoor Air Quality dampness and mould.

'곰팡이' 카테고리의 다른 글
| 아플라톡신 B1의 BBB 투과와 정서, 학습 장애 연관성 (1) | 2025.09.17 |
|---|---|
| 패툴린(Patulin)의 뇌 독성 과일 곰팡이 독소의 신경 손상 효과 (0) | 2025.09.02 |
| 곰팡이 흡입에 따른 신경면역 정서기능 이상 실험 모델 분석 (3) | 2025.08.26 |
| 재택근무 시대 실내 공기 질과 인지 기능 변화 연관성 (0) | 2025.08.21 |
| 습윤 주거 환경과 아동의 신경 면역 발달 연관성 (0) | 2025.08.21 |
| 곰팡이 노출이 신경 기분 장애와 연관된 분자 수준 (0) | 2025.08.20 |
| 곰팡이로 인한 신경 흥분 및 감각기능 장애 실제 데이터 분석 (0) | 2025.08.20 |
| 곰팡이로 인한 증후군-신경퇴행성 질환과 유사 증상 비교 (0) | 2025.08.19 |



